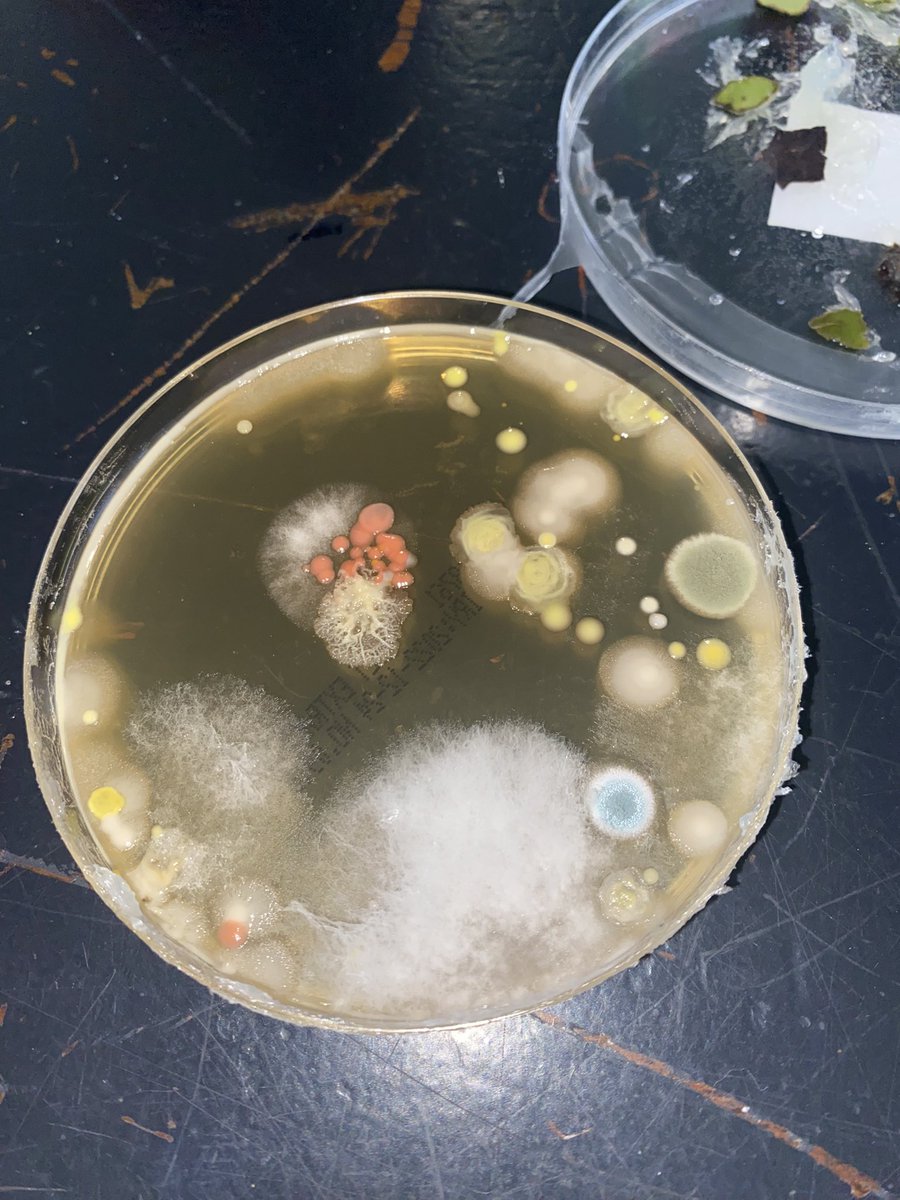
MissNCollier's tweet image. 5th Years got excellent results in their Biology practical on growing leaf yeast on starch agar plates. Practising their aseptic and sterilisation techniques while handling microorganisms! #PDSTBiology #LeavingCertBiology #PracticalWork @HolyChildCS
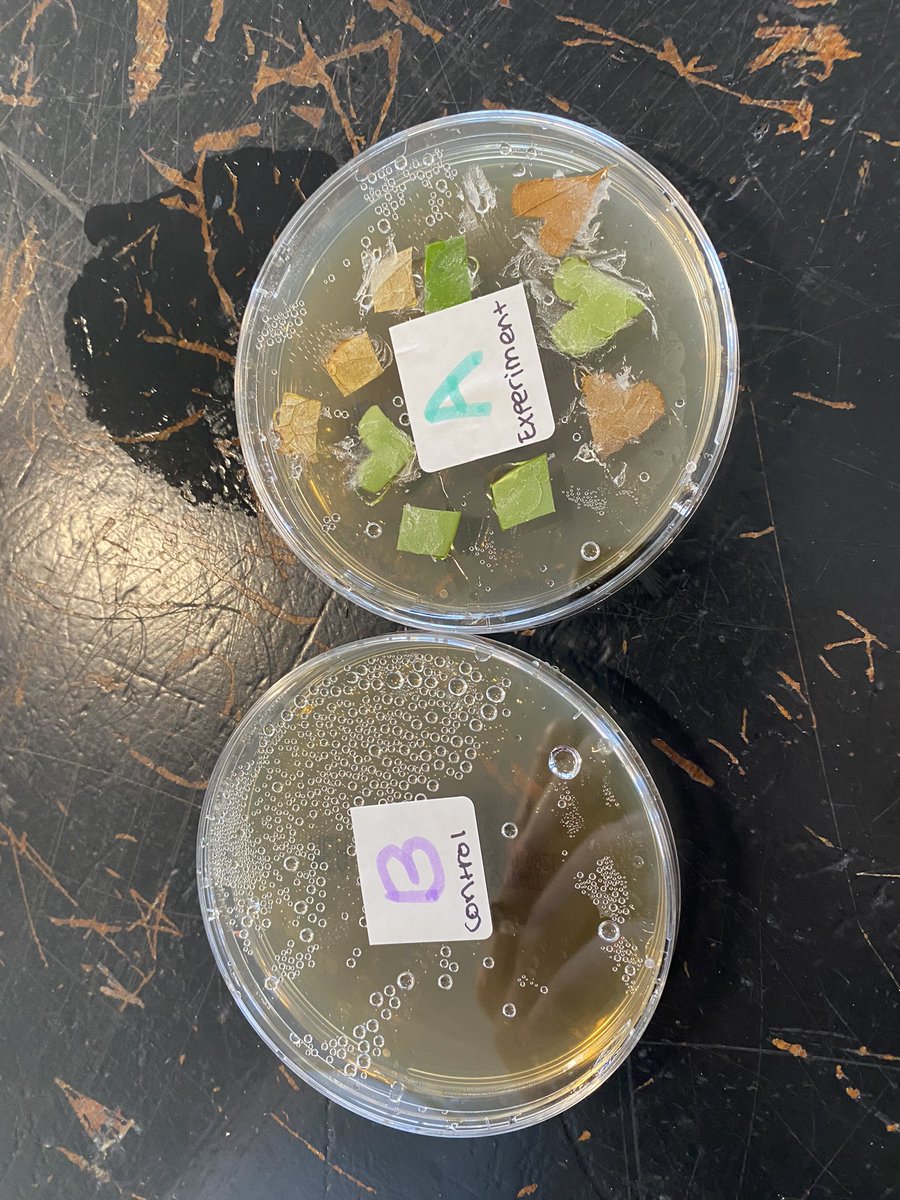
MissNCollier's tweet image. 5th Years got excellent results in their Biology practical on growing leaf yeast on starch agar plates. Practising their aseptic and sterilisation techniques while handling microorganisms! #PDSTBiology #LeavingCertBiology #PracticalWork @HolyChildCS

#practicalwork 검색 결과
We having been working on mass this week in Maths and really enjoyed getting practical #mass #practicalwork #mathsinaction




All worthwhile! Our year 12 chemists @Thomas_Alleynes busy making haloalkanes. First time using Quickfit & no breakages! Loving the new labs that make this possible #chemistry #practicalwork #happydays

This practical smelt lovely! 🥝 S2 pupils successfully extracted DNA from kiwi fruit cells this afternoon 🥝 #labskills #practicalwork #fruitcells #dnaextraction #biology #cells #dna #inheritance #life #science




7V demonstrating excellent engagement in the workshop while producing side 1 of their crane project. Supportive teamwork and lots of questions encouraged great outcomes. #practicalwork #maidavaleschooldt #structures




کار عملی پروژه «کابل جدید» امروز (پنج شنبه، ۲۶ اسد) با اشتراک مقامات بلند رتبه امارت اسلامی افغانستان طی مراسمی در کابل آغاز شد. #ArianaNews #NewKabulProject #PracticalWork
Clock work in Maths with Mr Daly for Year 3 ⌚️⏱🕰⏰ Learning to tell the time is a great skill. #practicalwork #learningwhilstdoingit

Slime making at the Highfield Adolescent Unit just before half term. #Slime #PracticalWork @OxfordHealthNHS

1.1 did a great job "creating" metamorphic rocks today 👏 #science #practicalwork #rocks #metamorphic #rockcycle #heatandpressure🔥🌋 🏔 🏞


A sneak peek of our work with our second year students this week. This is a caddisfly larva that incorporates stones into its pupal case, and also incorporates forensic evidence such as fibres! #practicalwork #forensicfacts #icjs

Yr9 have started the new term on a human biology topic: receptors & the nervous system 👁️🧠#practicalwork #biology




Our budding electronic engineers tried their hands at some soldering yesterday #engineering #practicalwork #electronics

Behind the scenes of the MDP Advisors at work. #Marketingpractice #practicalwork #socialmediamarketing #digitalmarketing

5th Years got excellent results in their Biology practical on growing leaf yeast on starch agar plates. Practising their aseptic and sterilisation techniques while handling microorganisms! #PDSTBiology #LeavingCertBiology #PracticalWork @HolyChildCS




It’s Post 16 Taster day @doncaster_utc for @Hungerhill Y11 students and we are getting Technical! #sixthform #practicalwork #wearedoncastrutc




8C had great fun today testing for glucose with @RCCS_Numeracy. An excellent set of results #Practicalwork #LoveScience


8V tackling soldering, drilling and filing to make their electronic fan. A fantastic practical session with some excellent peer support demonstrated. Well done to all. #practicalwork #maidavaleschooldt #kitronik




Most of these "jobs" aren't even needed in the first place #practicalwork #uselesseaters
Practical work experience be like- #Practicalwork #skills #experience #Practicalworkexperience #work #ShowYourSkills #Talent #funny #funnymemes #funnyvideo #Viral #Viralvideos #Viralmeme #Viralpost #memes
CT University's Department of Design and Innovation hosted an insightful session on XR and AI with Inderjit Singh (USA), highlighting their transformative impact on the future of technology. #CTU #PracticalWork #KnowledgeSharing #LearningMatters #AI #XR #CTUniversity #TeamCT




#ScienceInLife ... #PracticalWork #ExperientialLearning #Teacher #Nepal #SchoolEducation ......Salute! Madhav Guru. youtu.be/vYlCaD_00GI?si…
youtube.com
YouTube
"शिक्षकले राजनीति नगरे हुँदैन? -हुँदैन"। किन नि? Vikalpa with Madhav...
SPA Vijayawada's PG Construction Management students gained practical insights at The Trilight. Check out their hands-on learning experiences! #thetrilight #students #practicalwork #experiencetheengineering #engineeringlife #designingbuildings #hyderabad #luxuryrealestate




Isla and Evie hard at work in the Biology lab this week #practicalwork 🧪🦋⭐️🤎
All worthwhile! Our year 12 chemists @Thomas_Alleynes busy making haloalkanes. First time using Quickfit & no breakages! Loving the new labs that make this possible #chemistry #practicalwork #happydays

We having been working on mass this week in Maths and really enjoyed getting practical #mass #practicalwork #mathsinaction




अगले साल 4 जनवरी को खुल सकते हैं स्कूल! ICSE Board ने सभी राज्यों के मुख्यमंत्रियों को लिखा पत्र m.punjabkesari.in/education-and-… #ICSEBoard #OpenSchool #Practicalwork #projectwork #SUPWwork #Covid-19 #ChiefMinisters #UnionTerritories

Clock work in Maths with Mr Daly for Year 3 ⌚️⏱🕰⏰ Learning to tell the time is a great skill. #practicalwork #learningwhilstdoingit

Slime making at the Highfield Adolescent Unit just before half term. #Slime #PracticalWork @OxfordHealthNHS

This practical smelt lovely! 🥝 S2 pupils successfully extracted DNA from kiwi fruit cells this afternoon 🥝 #labskills #practicalwork #fruitcells #dnaextraction #biology #cells #dna #inheritance #life #science




A sneak peek of our work with our second year students this week. This is a caddisfly larva that incorporates stones into its pupal case, and also incorporates forensic evidence such as fibres! #practicalwork #forensicfacts #icjs

Our budding electronic engineers tried their hands at some soldering yesterday #engineering #practicalwork #electronics

1.1 did a great job "creating" metamorphic rocks today 👏 #science #practicalwork #rocks #metamorphic #rockcycle #heatandpressure🔥🌋 🏔 🏞


Yr9 have started the new term on a human biology topic: receptors & the nervous system 👁️🧠#practicalwork #biology




5th Years got excellent results in their Biology practical on growing leaf yeast on starch agar plates. Practising their aseptic and sterilisation techniques while handling microorganisms! #PDSTBiology #LeavingCertBiology #PracticalWork @HolyChildCS

Behind the scenes of the MDP Advisors at work. #Marketingpractice #practicalwork #socialmediamarketing #digitalmarketing

Yr10 studying the circulatory system as part of their #AQA GCSE course🫀#practicalwork #activelearning




7V demonstrating excellent engagement in the workshop while producing side 1 of their crane project. Supportive teamwork and lots of questions encouraged great outcomes. #practicalwork #maidavaleschooldt #structures




Today we are Castleton Health Centre for #MensHealthDay Here 9-12 come down & say hello Hear about @HMRCircleCIC @GTCRochdale @Giveandtakecare #VolunteerDriversService #PracticalWork #CircleFamily


8C had great fun today testing for glucose with @RCCS_Numeracy. An excellent set of results #Practicalwork #LoveScience


Something went wrong.
Something went wrong.
United States Trends
- 1. National Guard 179K posts
- 2. Thanksgiving 450K posts
- 3. Liverpool 128K posts
- 4. Arsenal 399K posts
- 5. Slot 109K posts
- 6. Bayern 213K posts
- 7. Neuer 21.5K posts
- 8. Frank Ragnow 7,086 posts
- 9. #InfoSecVPN 1,010 posts
- 10. Martinelli 25.3K posts
- 11. Konate 15.8K posts
- 12. Anfield 22.1K posts
- 13. Blood 158K posts
- 14. Declan Rice 14.3K posts
- 15. Mbappe 111K posts
- 16. #ARSBAY 8,362 posts
- 17. Arteta 29K posts
- 18. #COYG 6,244 posts
- 19. Olympiacos 27.5K posts
- 20. Patrick Morrisey 3,821 posts



















































